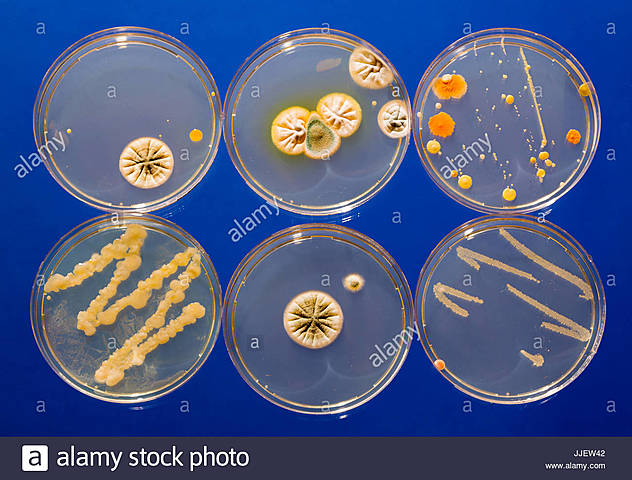
Gibson Et Al

-
Los orígenes de genéticas mienten en el revelado de teorías de la evolución. Era en 1858 que el origen de la especie y cómo la variabilidad de la especie fue desarrollada después del trabajo de investigación de Charles Darwin y de Wallace. Describieron cómo la nueva especie se presentó vía la evolución y cómo la selección natural ocurrió para desarrollar nuevas formas. Sin embargo no sabían que los genes del papel tuvieron que jugar en este fenómeno.
-
Aproximadamente al mismo tiempo Gregor Mendel, monje austriaco, realizaba experimentos extensos en herencia y genéticas de las instalaciones de guisante de olor. Él describió la unidad de la herencia como partícula que no cambia y se pasa conectado al descendiente. Su trabajo es de hecho la base de entender los principios de genéticas incluso hoy. Por lo tanto, conocen a Gregor Mendel como el padre de la genética.
-
Con la colaboración de MacLeod y McCarty,Avery demostró que aquel principio transformante de Griffith era el ADN: la transformación persistía al tratar los extractos bacterianos con enzimas que rompían las proteínas, mientras que desaparecía al degradar el ADN.Se adelantaba a su tiempo: la inercia que asignaba la herencia genética a las proteínas aún era muy potente,y el propio investigador siempre se abstuvo de extrapolar sus resultados como una propiedad universal de los genes
-
Analizó las base nitrogenadas del ADN en diferentes formas de vida, concluyendo que, la cantidad de purinas no siempre se encontraban en proporciones iguales a las de las pirimidinas (contrariamente a lo propuesto por Levene), la proporción era igual en todas las células de los individuos de una especie dada, pero variaba de una especie a otra.Muchos científicos se interesaron en descifrar la estructura del ADN como,Francis Crick, James Watson, Rosalind Franklin, y Maurice Wilkins.
-
Demostraban que eran las moléculas de DNA y no las proteínas las portadoras de la información genética, es necesario comprender el mecanismo de replicación de los bacteriófagos.Estudiaron bacteriófagos, virus que atacan bacterias. Los fagos que utilizaban eran simples partículas compuestas de proteína y ADN, con sus estructuras externas hechas de proteínas y el núcleo interno compuesto por ADN.
-
Obtuvo una fotografía de difracción de rayos X que reveló, de manera inconfundible, la estructura helicoidal de la molécula del ADN.
-
Descubrieron que haciendo cristalizar la molécula y sometiéndola a haces de rayos X de los que se estudiaba los distintos modos de difracción era posible discernir pistas acerca de la estructura de doble hélice del ADN.La estructura fue propuesta como el modelo que mejor se acomodaba a las imágenes de los rayos X de Rosalind Franklin Explican que cada parte de ADN es un doble espejo del que tiene enfrente,lo que explica por qué el ADN puede copiarse y reproducirse.
-
Severo empezó a ver cómo el ADN funcionaba dentro de la célula,en qué mecanismo estaba implicado.Marsal y Har descubrieron el código genético que la secuencia de ARN UUU codifica el aminoácido fenilalanina.Posteriormente,Har demostró que la secuencia repetitiva de nucleótidos UCUC codifica la secuencia de aminoácidos serina-leucina.El código genético había sido completamente descifrado.Se encontró que cada grupo de tres nucleótidos corresponde a un aminoácido.
-
El desarrollo de la PCR, la técnica de replicación de ADN que se utiliza desde hace más de 25 años para hacer test de paternidad, identificar cadáveres y detectar enfermedades
-
Examinando unas placas de rayos-X realizadas sobre un experimento de ADN cuyas muestras se obtuvieron de varios miembros de la familia de su ayudante,advirtió inesperadamente las similitudes y diferencias en el ADN de los distintos miembros del conjunto.Había descubierto la huella genética o del ADN.La huella genética y el perfil de ADN
-
Intenta analizar toda la secuencia del ADN entera de los seres vivos,para ver qué parte del ADN codifica ajenes y esos ajenes qué proteínas producen.Con este proyecto podemos conocer todo el ADN de cualquier ser humano.Gracias a este proyecto actualmente el ADN está totalmente secuenciado pero aún no sabemos con certeza a todos los genes que codifican,pero si hay un mapeo bastante claro y ideas de dónde están ubicados genes que codifican para diversas enfermedades.Se ha ido manipulando
-
Este período anunció el concepto de biología molecular y de genética molecular. Las diversas tecnologías avanzadas hicieron su manera en base de conocimiento alrededor de este tiempo. Esto incluyó biología molecular, tecnología de DNA recombinante, y métodos de la biotecnología.
-
Gibson y sus compañeros publicaron la primera síntesis del primer genoma bacteriano,se pudo hacer el primer ADN artificial de una bacteria
-
Se consiguió de forma artificial general el ADN de una levadura
-
Francis Crick escribió una carta a su hijo sobre lo que había descubierto,de cual era la estructura del ADN,de cómo estaba formaba...La importancia que tiene
Looking for a timeline maker?
Create timelines for projects, roadmaps, history, lessons, legal cases, and stories with Timetoast. Timetoast is a timeline maker for work, school, research, and stories.